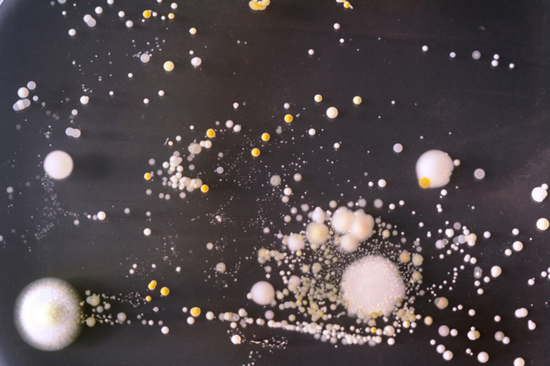

Биологи установили какие микробы скапливаются на мобильном телефоне

Студенты-биологи из университета Суррея любопытства ради установили, какие микробы скапливаются на поверхности корпуса современного мобильного телефона.
В ходе эксперимента телефон, активно использовавшийся определенное время, был помещен в чашку Петри. Через некоторое время телефон извлекли, и изучили культуры бактерий, обитающие на его поверхности.
Оказалось, что мобильный телефон современного человека представляет собой миниатюрную помойку. Уже через несколько дней поверхность телефона покрылись самыми разными микроорганизмами, в том числе и потенциально смертельными для человека.
Все это многообразие ежедневно кочует через руки в рот
Так, в ходе исследований на среднестатистическом телефоне обнаружились возбудители золотистого стафилококка, герпеса, кандидоза, экземы и других малоприятных заболеваний. В результате исследования биологи сделали выводы, что собственный телефон лучше не передавать посторонним, а при необходимости осуществить звонок с чужого телефона, протирать его поверхность хотя бы гигиеническими салфетками.
Комментируя огромное количество бактерий, покрывающих современные телефоны, исследователи отметили, что подавляющее большинство микробов, живущих на мобильных устройствах, составляют те же микроорганизмы, что живут на коже человека. Тем не менее, активно передавая телефон из рук в руки, пользователь может превратить его в настоящий рассадник заболеваний.




